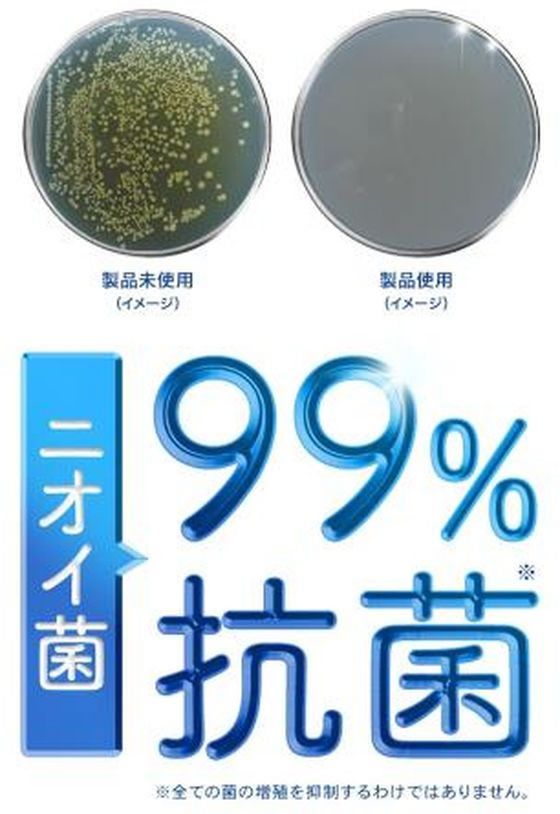

会員様限定 5,400円(税込)以上お買い上げで送料無料!
カテゴリから探す
- 紙袋(3,827)
- 箱(ギフトボックス)(5,955)
- ラッピング用品(34,367)
- ポリ袋(20,212)
- OPP袋(透明袋)(2,452)
- 食品容器・食品包装資材(55,348)
- キッチン用品・厨房用品(239,206)
- 衛生用品・清掃用品(66,791)
- 業務用食品・ギフト(17,819)
- 店舗用品(121,178)
- 文房具・事務用品(167,905)
- パソコン・OA用品(35,426)
- イベント用品(4,040)
- 手芸用品(22,766)
- フラワーアレンジメント資材・フラワーベース(18,196)
- 農業資材・園芸用品(9,876)
- 梱包資材(16,496)
- 物流資材・工場資材(586,160)
- 作業服・ワークウェア・安全靴(156,041)
- 医療・介護用品(56,689)
- 家電・店舗設備(17,597)
- 生活用品・日用雑貨(31,486)
- 研究開発用品・クリーンルーム用品(33,224)
- シモラボ〈特注品〉(2,906)
- シモラボ オフィス(1,884)
ドクター・ショール 消臭・抗菌靴スプレー 無香性 40ml 1本(ご注文単位1本)【直送品】
価格:¥719(税込)
価格(個単価): ¥719(税込)
- 商品コード:
- 2501600907891
- メーカー品番:
- FJ867MD
- 型番:
- 349483
次回の入荷は未定です
商品詳細
-
- 商品説明
- 強力な天然消臭成分でしっかりニオイを消臭。コンパクトサイズ。 あらゆるタイプの履物に使える、消臭、抗菌の靴スプレーのコンパクトサイズ。消臭、抗菌、防カビ成分「コーキンマスター」が靴の中のニオイの元となる細菌、カビの繁殖を抑えます。すでに発生しているニオイも瞬時に除去。天然消臭成分を配合した無香性タイプ。 ●無香性●注文単位:1本※メーカーの都合により、パッケージ・仕様等は予告なく変更になる場合がございます。
-
- メーカー品番
- FJ867MD
-
- 型番
- 349483
-
- 小箱
- 1個(1個)
発送元
文具・事務用品関連02

- 本州
- ¥3,980以上で送料無料
¥3,980未満の場合¥880 - 北海道
- ¥3,980以上で送料無料
¥3,980未満の場合¥1,100

沖縄・離島配送不可

返品不可・日曜祝日指定不可
靴消臭剤の人気商品との比較
商品名
価格(税込)
サイズ
発送元
レビュー

ドクター・ショール 消臭・抗菌靴スプレー 無香性 40ml 1本(ご注文単位1本)【直送品】
¥719
【直送品】文具・事務用品関連02

※ご注文後、在庫がない場合キャンセル等のご連絡をさせていただきます。